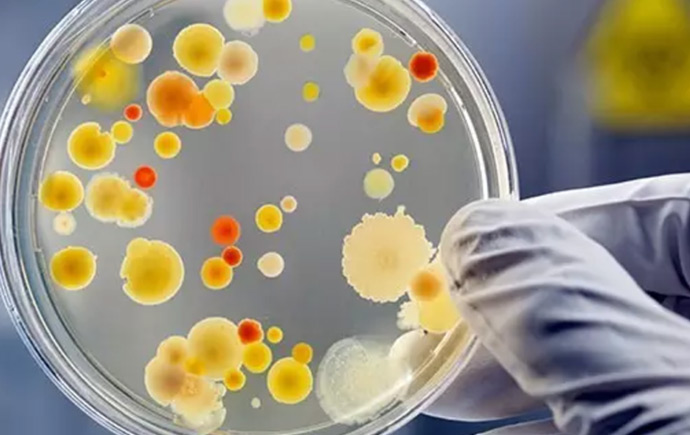

在研究方面,我校以卓越性、相关度、影响力为原则,精心设计科研计划,所涉及科研领域超过150个。很多项目都与人们的生活息息相关,包括:
世界首例体外人工受精(IVF)
1973年蒙纳士大学开创了世界上第一例体外受精,5年后,根据蒙纳士大学生育与发展研究所Alan Trounson教授和Carl Wood教授的研究,世界首位试管婴儿Louise Brown于英国诞生。

对抗流感的药物瑞沙乐(Relenza)
1980年代,蒙纳士大学成功研发出世界上首个成功抗击流感的药物——瑞沙乐。
消除登革热项目
蒙纳士大学领导的消除登革热项目成功利用了名为沃尔巴克氏体(Wolbachia)的天然细菌削弱由蚊子传播的对人类有害的病毒,例如登革热、基孔肯雅和寨卡病毒。

催生素吸入器
蒙纳士大学的研究人员研发出一款新型催生素配方——在室温下性状稳定,抗降解;并为其设计了一种吸入器,使其可通过吸入吸收,无需注射。该研究使催产素得以更快地普及到发展中国家,特别是农村地区,挽救成千上万产妇的生命。

城市贫民窟振兴
蒙纳士可持续发展研究所与主要合作伙伴亚洲开发银行、惠康信托联手推出了一项为期五年的"RISE"(“复兴非正式居所及环境”)计划,它将致力于改造水务基础设施、水务管理和卫生习惯,重建印尼和斐济的24个简易棚户区,以提升当地居民的健康和福祉。

仿生眼
蒙纳士视觉小组的成员开发了一种仿生视觉系统,以帮助因视神经受损而丧失视力的病患重新获取视觉信息。

喷气发动机的增材制造
蒙纳士大学成功运用3D打印技术制造出世界上首个可运作的飞机引擎,并已与中国商用飞机公司签署合作协议,共同研发专门用于航空航天应用的新型3D打印合金元件,包括设计和建造中国商用飞机公司的新C919商用大型客机。

水敏型城市
蒙纳士的这一创新研究,将帮助世界各地因气候变暖而面临干旱、洪水、水道退化等问题的城市管理其水资源。该研究项目享有很高的国际声誉。

当前,蒙纳士凭借其卓越的研究和教学成果,在国内外赢得了令人称羡的赞誉。学校拥有高学历的研究学生4773人,共计在国际顶级期刊nature发表文章数量为402篇,2016年研究收入为3.53亿澳元。并且,在2018年《世界大学学术排名(ARWU)》(“上海排名”)中,位居第91位;2019年《泰晤士高等教育世界大学排名》中,位居世界排名前百强的大学 (第84位)。
更多有关蒙纳士大学科研,请阅览蒙纳士科研领域和能力。
